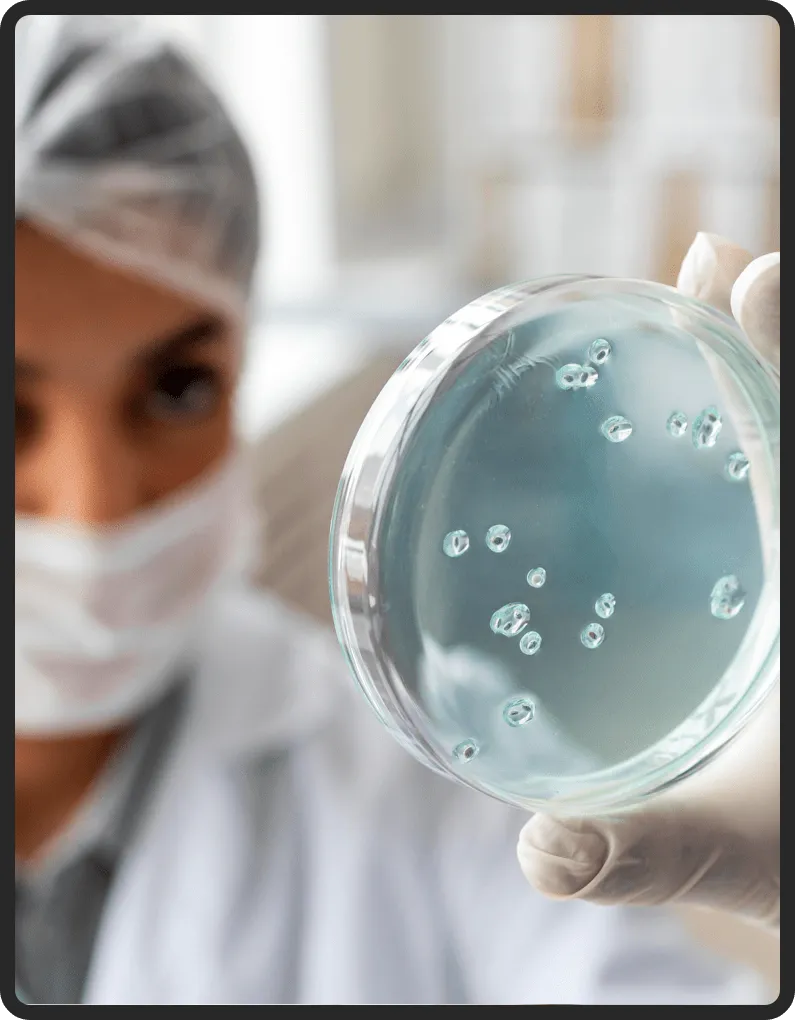

NEOTONICS REVIEW
Neotonics Review 2026: Does It Really Support Skin Rejuvenation and Gut Health – Scam or Legit?
REVIEW UPDATED
Does Neotonics Really Work? We carefully analyzed it to bring you the truth about Neotonics.
👉 Please read until the end to draw your own conclusion.

Does Neotonics Really Work? We carefully analyzed it to bring you the truth about Neotonics.
👉 Please read until the end to draw your own conclusion.
Neotonics Review 2026: Does It Really Support Skin Rejuvenation and Gut Health – Scam or Legit?
REVIEW UPDATED

Does Neotonics Really Work? We carefully analyzed it to bring you the truth about Neotonics.
👉 Please read until the end to draw your own conclusion.
Does Neotonics Still Worth It In 2026?
In 2026, one of the biggest health and beauty concerns is premature skin aging — caused by stress, pollution, poor diet, and especially an imbalanced gut. Wrinkles, sagging skin, loss of elasticity, and dullness are no longer just “signs of age,” but consequences of a deeper imbalance in the body.
That’s where Neotonics stands out. It’s not a cream or serum that only works on the surface. Instead, it’s a powerful probiotic formula that acts from the inside out — first restoring gut health and then accelerating skin cell turnover, leaving your skin smoother, firmer, and visibly younger.
What keeps Neotonics highly recommended is its unique combination of probiotic strains + plant-based nutrients, designed to improve digestion, boost nutrient absorption, and naturally rejuvenate the skin.
With thousands of users reporting improvements in just a few weeks — including brighter skin tone, fewer wrinkles, better digestion, and overall vitality — Neotonics remains one of the best choices in 2026 for anyone who wants true, lasting skin renewal without expensive treatments.
Pros And Cons

PROS
✅ Targets both gut health and skin aging at the root cause
✅ Unique probiotic blend with natural plant-based ingredients
✅ Supports digestion and nutrient absorption for glowing skin
✅ Made in the USA in GMP-certified facilities
✅ 100% natural, non-GMO, stimulant-free
✅ Positive user reviews and strong scientific background
✅ Works for men and women of all ages
✅ 60-day money-back guarantee
✅ Free from allergens and artificial fillers
CONS
❌ Only available online via the official website
❌ Results may vary depending on age and lifestyle
❌ Requires consistent daily use for optimal results
Special Offer Today: 51% OFF + Free Shipping!
Neotonics Scam Alert (How To Avoid The Scam)
Neotonics Review

Unfortunately, many people fall for fake versions of Neotonics sold on Amazon, Walmart, or eBay. These imitations may look similar, but they contain cheap fillers and fake ingredients that can harm your health.
⚠️ To protect yourself:
👉 Only buy Neotonics from the Official Website. That way you’re guaranteed to receive the authentic formula, full benefits, and the 60-day money-back guarantee.
Special Offer Today: 51% OFF + Free Shipping!
What is Neotonics?
Neotonics Review
Neotonics is a premium probiotic supplement formulated to target both gut balance and skin health. Its unique blend of 500 million CFU probiotics + natural antioxidants helps:
Restore gut microbiome balance
Boost digestion and nutrient absorption
Accelerate skin cell turnover for younger-looking skin
Reduce fine lines, wrinkles, and sagging
Support natural collagen production
Unlike creams that only mask the problem, Neotonics works internally, rejuvenating the body’s ecosystem so that healthy, glowing skin becomes the natural outcome.
Perfect for:
🌿 People struggling with premature wrinkles and dull skin
🌿 Adults with digestive issues that affect skin health
🌿 Anyone seeking a non-invasive alternative to costly skincare procedures
So What Are You Waiting for?
Place your Order with 51% OFF on the Official
Neotonics™ Website!
How Does Neotonics Work?
(What Does The Science Say About Neotonics? )
The secret of Neotonics lies in its gut-skin connection. Science has shown that when your gut microbiome is imbalanced, nutrient absorption slows down, inflammation rises, and skin cell renewal declines — leading to wrinkles, sagging, and dull complexion.
Neotonics works by:
Rebalancing the gut microbiome with powerful probiotics.
Improving nutrient absorption so the skin receives the vitamins and minerals it needs to repair itself.
Accelerating cellular turnover, replacing old, damaged skin cells with new, healthy ones faster.
Supporting collagen and elastin production, giving skin firmness and elasticity.
The result? Skin that not only looks younger but truly regenerates from within.
So What Are You Waiting for?
Place your Order with 51% OFF on the Official
Neotonics™ Website!
Real Neotonics Users
Life Changing Results

✨ “After 3 weeks of Neotonics, my skin looks brighter, and even my digestion improved. I wake up looking fresh instead of tired. Totally worth it!”
Emily R., 48 – Austin, TX
✅ Verified Purchase
03/12/2025 – Purchased 6 Bottles Package

✨ “I tried expensive creams for years, but nothing worked like Neotonics. My fine lines are fading, and I feel younger overall. And the bonus: no more bloating!”
Martha P., 55– New York, NY
✅ Verified Purchase
08/12/2025 – Purchased 6 Bottles Package
Our Customers Say

Based On +20.000 Reviews!
Powerful Ingredients of Neotonics
Neotonics uses a carefully selected blend of probiotics and natural extracts, all backed by skin and gut health science:
🥦 500 Million CFU Probiotic Blend – Restores gut balance, improves digestion, and supports nutrient absorption essential for skin renewal.
🍎 Babchi (Psoralea corylifolia) – Known as the “natural retinol,” helps boost collagen and reduce fine lines.
🌸 Fenugreek – Supports skin hydration and elasticity while aiding digestion.
🍊 Lemon Balm – Calms inflammation, supports smoother skin, and enhances relaxation.
🍄 Slippery Elm Bark – Protects gut lining and improves nutrient assimilation.
🌱 Inulin & Dandelion Root – Prebiotic fibers that feed good gut bacteria, improving overall digestive health.
🌺 Fennel & Organic Ceylon Ginger – Rich in antioxidants, they reduce oxidative stress and fight signs of aging.

Safety & Side Effects
Neotonics Review
Neotonics is made from 100% natural, non-GMO ingredients. It is stimulant-free, safe for daily use, and manufactured in a GMP-certified facility in the USA.
So far, there have been no significant side effects reported. Some users may experience mild digestive adjustments in the first days, as the gut microbiome rebalances — a positive sign that the formula is working.
Not recommended for pregnant or breastfeeding women without medical advice. Always consult your doctor if you have specific conditions.

So What Are You Waiting for?
Place your Order with 51% OFF on the Official
Neotonics™ Website!
Neotonics Benefits
Neotonics Review
✅ Reduces wrinkles and fine lines naturally
✅ Boosts skin cell turnover for smoother, younger-looking skin
✅ Improves gut health for better digestion and nutrient absorption
✅ Supports collagen & elastin production
✅ Brightens skin tone and reduces dullness
✅ Protects against oxidative stress
✅ Promotes firmer, glowing, youthful skin
✅ 60-Day Money-Back Guarante
So What Are You Waiting for?
Place your Order with 51% OFF on the Official
Neotonics™ Website!
Neotonics – Refund Policy

Every single Neotonics supplement purchase is backed with a 60-day 100% money-back guarantee. So if you are not impressed with the results, you can simply choose this refund policy for getting your complete money back. Even though the Neotonics formula is made using natural ingredients its effect on individuals may vary. If you have used the supplement for the suggested period of time and didn’t get the expected results then the refund policy is yours to claim.
The process is quite simple, just send an email or call the customer service of the Neotonics supplement regarding your disinterest within the first 60 days of your purchase. You may have to return the bottles to them, once they got them the refund will be issued from the manufacturer’s side.
So What Are You Waiting for?
Place your Order with 51% OFF on the Official
Neotonics™ Website!
Claim Your Discounted Neotonics
Below While Stocks Last!


Frequently Asked Question
1. How long does it take to see results with Neotonics?
Most users notice improvements in digestion and skin brightness within the first 2–3 weeks. Deeper anti-aging results typically appear after consistent use for 60 days.
2. Are there any side effects?
Neotonics is natural and safe. Some users may experience mild digestive adjustment at the beginning, but this usually resolves quickly.
3. Can I take Neotonics with other supplements or medications?
In most cases, yes. However, if you’re under prescription medication or have medical conditions, consult your doctor.
4. Do I have to use Neotonics forever?
Not necessarily. Many users take it for 3–6 months to restore gut-skin balance and then maintain results with a healthy lifestyle.
5. Where can I buy Neotonics safely?
Only from the Official Website. That’s the only way to ensure you get the genuine formula and full money-back guarantee.
Final Verdict of Neotonics Review
After testing and reviewing countless supplements, Neotonics truly stands out. It’s not just another “skin pill” — it’s a scientifically backed formula that attacks the root cause of skin aging: poor gut health and slowed cell renewal.
The biggest difference? Instead of masking imperfections, Neotonics regenerates your skin naturally from within. Users report looking years younger, with smoother skin, improved digestion, and renewed confidence.
If you’re tired of creams that don’t deliver and want a real, lasting solution for youthful skin, Neotonics is worth trying.
Special Offer Today: 51% OFF + Free Shipping!
The statements made on our websites have not been evaluated by the FDA (U.S. Food & Drug Administration). Our products are not intended to diagnose, cure or prevent any disease. The information provided by this website or this company is not a substitute for a face-to-face consultation with your physician, and should not be construed as individual medical advice. The testimonials on this website are individual cases and do not guarantee that you will get the same results. Due to the nature of this product and to protect the privacy of the individuals, actual names and photographs of the individuals depicted in the testimonials have been changed. Individuals are remunerated.
Copyright © 2026 Neotonics Review | All Rights Reserved
